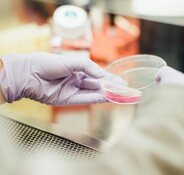

Valneva SE's (VALN:NASDAQ; VLA:FRA) vaccine against chikungunya, called Ixchiq (VLA1553), showed the presence of antibodies in adults 24 months after injection, according to recent data from the VLA1553-303 study, H.C. Wainwright & Co. analyst Edward White reported in a December 4 research note.
"These positive 24-month antibody persistence data, which are in line with positive 12-month data previously reported last December, are expected to supplement the existing U.S. Food and Drug Administration (FDA) approval and ongoing regulatory approval processes," White wrote. He explained that the FDA, on Nov. 9, granted Ixchiq accelerated approval for individuals 18 years of age and older at increased risk of exposure to chikungunya.
Also, the agency awarded Valneva a tropical disease priority review voucher (PRV), which, White purported, could be worth around US$100 million (US$100M) based on the most recent PRV sale of US$103M."
136% Possible Gain
The France-based specialty vaccine firm currently has a stock price of about US$11.01 per share, which compares to H.C. Wainwright's target price of US$26 per share, noted White.
Inherent in these figures is the potential for a 136% return on investment.
Valneva is a Buy.
High Seroresponse Rate
White reported that study VLA1553-303, which included a follow-up at 24 months, met the primary endpoint, with Ixchiq demonstrating a 97% seroresponse rate two years post-vaccination.
"Antibody levels remained high and well above the seroresponse threshold," the analyst wrote.
Further, antibody levels were as robust in adults age 65 and older as they were among their younger counterparts.
During the 24-month follow-up period, no safety concerns were reported.
Going to Market
Valneva plans to commercialize Ixchiq in the U.S. and, according to White, believes it has enough product and a team ready to proceed.
H.C. Wainwright estimates Ixchiq sales will hit €40M in 2024 and increase thereafter, reaching €350M in 2028.
Looking to the future of the annual global market for chikungunya vaccines, Valneva predicts it will surpass US$500M by 2032, White reported.
Near-Term Catalysts
Along with potentially launching Ixchiq in the U.S. in early 2024, Valneva anticipates receiving a recommendation for this vaccine from the Advisory Committee on Immunization Practices within the U.S. Centers for Disease Control and Prevention sometime in Q1/24.
Valneva is seeking a green light for Ixchiq elsewhere in the world, too. Currently, the European Medicines Agency and Health Canada are reviewing marketing applications for it. Approvals could happen around mid-2024.
Also on the horizon are results from the ongoing Phase 3 study of Ixchiq in adolescents in Brazil. Valneva will use the positive pivotal immunogenicity data reported from this trial last month in support of its request for label expansion in the States and for licensure in Brazil.
| Want to be the first to know about interesting Biotechnology / Pharmaceuticals investment ideas? Sign up to receive the FREE Streetwise Reports' newsletter. | Subscribe |
Important Disclosures:
- Doresa Banning wrote this article for Streetwise Reports LLC and provides services to Streetwise Reports as an independent contractor.
- The article does not constitute investment advice. Each reader is encouraged to consult with his or her individual financial professional and any action a reader takes as a result of information presented here is his or her own responsibility. By opening this page, each reader accepts and agrees to Streetwise Reports' terms of use and full legal disclaimer. This article is not a solicitation for investment. Streetwise Reports does not render general or specific investment advice and the information on Streetwise Reports should not be considered a recommendation to buy or sell any security. Streetwise Reports does not endorse or recommend the business, products, services or securities of any company mentioned on Streetwise Reports.
- This article does not constitute medical advice. Officers, employees and contributors to Streetwise Reports are not licensed medical professionals. Readers should always contact their healthcare professionals for medical advice.
For additional disclosures, please click here.
Disclosures for H.C. Wainwright & Co., Valneva SE, December 4, 2023
This material is confidential and intended for use by Institutional Accounts as defined in FINRA Rule 4512(c). It may also be privileged or otherwise protected by work product immunity or other legal rules. If you have received it by mistake, please let us know by e-mail reply to unsubscribe@hcwresearch.com and delete it from your system; you may not copy this message or disclose its contents to anyone. The integrity and security of this message cannot be guaranteed on the Internet.
H.C. WAINWRIGHT & CO, LLC RATING SYSTEM: H.C. Wainwright employs a three tier rating system for evaluating both the potential return and risk associated with owning common equity shares of rated firms. The expected return of any given equity is measured on a RELATIVE basis of other companies in the same sector. The price objective is calculated to estimate the potential movements in price that a given equity could reach provided certain targets are met over a defined time horizon. Price objectives are subject to external factors including industry events and market volatility.
H.C. Wainwright & Co, LLC (the “Firm”) is a member of FINRA and SIPC and a registered U.S. Broker-Dealer.
I, Edward White , certify that 1) all of the views expressed in this report accurately reflect my personal views about any and all subject securities or issuers discussed; and 2) no part of my compensation was, is, or will be directly or indirectly related to the specific recommendation or views expressed in this research report; and 3) neither myself nor any members of my household is an officer, director or advisory board member of these companies.
None of the research analysts or the research analyst’s household has a financial interest in the securities of Valneva SE (including, without limitation, any option, right, warrant, future, long or short position).
As of November 30, 2023 neither the Firm nor its affiliates beneficially own 1% or more of any class of common equity securities of Valneva SE.
Neither the research analyst nor the Firm knows or has reason to know of any other material conflict of interest at the time of publication of this research report.
The research analyst principally responsible for preparation of the report does not receive compensation that is based upon any specific investment banking services or transaction but is compensated based on factors including total revenue and profitability of the Firm, a substantial portion of which is derived from investment banking services. The Firm or its affiliates did not receive compensation from Valneva SE for investment banking services within twelve months before, but will seek compensation from the companies mentioned in this report for investment banking services within three months following publication of the research report. The Firm does not make a market in Valneva SE as of the date of this research report.
The securities of the company discussed in this report may be unsuitable for investors depending on their specific investment objectives and financial position. Past performance is no guarantee of future results. This report is offered for informational purposes only, and does not constitute an offer or solicitation to buy or sell any securities discussed herein in any jurisdiction where such would be prohibited. This research report is not intended to provide tax advice or to be used to provide tax advice to any person. Electronic versions of H.C. Wainwright & Co., LLC research reports are made available to all clients simultaneously. No part of this report may be reproduced in any form without the expressed permission of H.C. Wainwright & Co., LLC. Additional information available upon request.
H.C. Wainwright & Co., LLC does not provide individually tailored investment advice in research reports. This research report is not intended to provide personal investment advice and it does not take into account the specific investment objectives, financial situation and the particular needs of any specific person. Investors should seek financial advice regarding the appropriateness of investing in financial instruments and implementing investment strategies discussed or recommended in this research report. H.C. Wainwright & Co., LLC’s and its affiliates’ salespeople, traders, and other professionals may provide oral or written market commentary or trading strategies that reflect opinions that are contrary to the opinions expressed in this research report.
H.C. Wainwright & Co., LLC and its affiliates, officers, directors, and employees, excluding its analysts, will from time to time have long or short positions in, act as principal in, and buy or sell, the securities or derivatives (including options and warrants) thereof of covered companies referred to in this research report. The information contained herein is based on sources which we believe to be reliable but is not guaranteed by us as being accurate and does not purport to be a complete statement or summary of the available data on the company, industry or security discussed in the report. All opinions and estimates included in this report constitute the analyst’s judgment as of the date of this report and are subject to change without notice. Securities and other financial instruments discussed in this research report: may lose value; are not insured by the Federal Deposit Insurance Corporation; and are subject to investment risks, including possible loss of the principal amount invested.